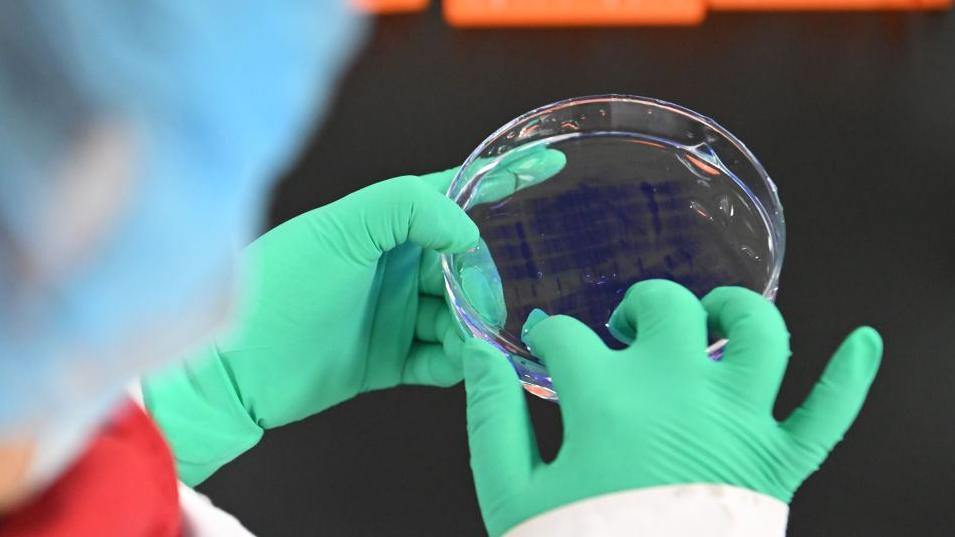

2026“国补”继续!几类补贴有变化 一文看懂
除了数码产品,家电补贴在2026年也继续推进,条件更聚焦于高能效产品。家电以旧换新只补贴1级能效或水效标准产品,不再补贴2级能效或水效标准的产品。

2026年育儿补贴开始申领 操作指南请查收
新一年育儿补贴线上申领的最大变化,是在去年的基础功能上增加了续领功能。也就是说,2025年已申领过育儿补贴且符合新一年继续申领条件的婴幼儿,其申领人可以进行续领申请。

数字人民币进入2.0版将带来哪些改变?一文深解→
2025年12月31日,工商银行、农业银行、建设银行、中国银行等六大行相继发布公告,自2026年1月1日起,将开立在该行的数字人民币实名钱包余额按照银行活期存款挂牌利率计付利息,计结息规则与活期存款一致。至此,经过十余年探索、试点,数字人民币进入2.0版。

看病缴费不用等!医保便捷支付体系力争3年左右建成
聚焦群众看病缴费“多次排队”“排长队”等堵点痛点,国家医保局办公室1月8日发布《关于大力推进刷脸支付、一码支付、移动支付、信用支付等便捷支付工作的通知》,明确加快推进刷脸支付、一码支付、移动支付、信用支付在各类医疗场景落地。
用药利好事关你我!国家医保药品“清单”一览
最新版医保药品目录已于2026年1月1日正式落地实施。此次调整有哪些新亮点?为参保人带来哪些利好?国家医保局7日进行了解读。

2026年适度宽松的货币政策将着力服务经济高质量发展
记者从中国人民银行了解到,2026年,我国将继续实施适度宽松的货币政策,把促进经济稳定增长、物价合理回升作为货币政策的重要考量,灵活高效运用降准降息等多种货币政策工具,保持流动性充裕。








